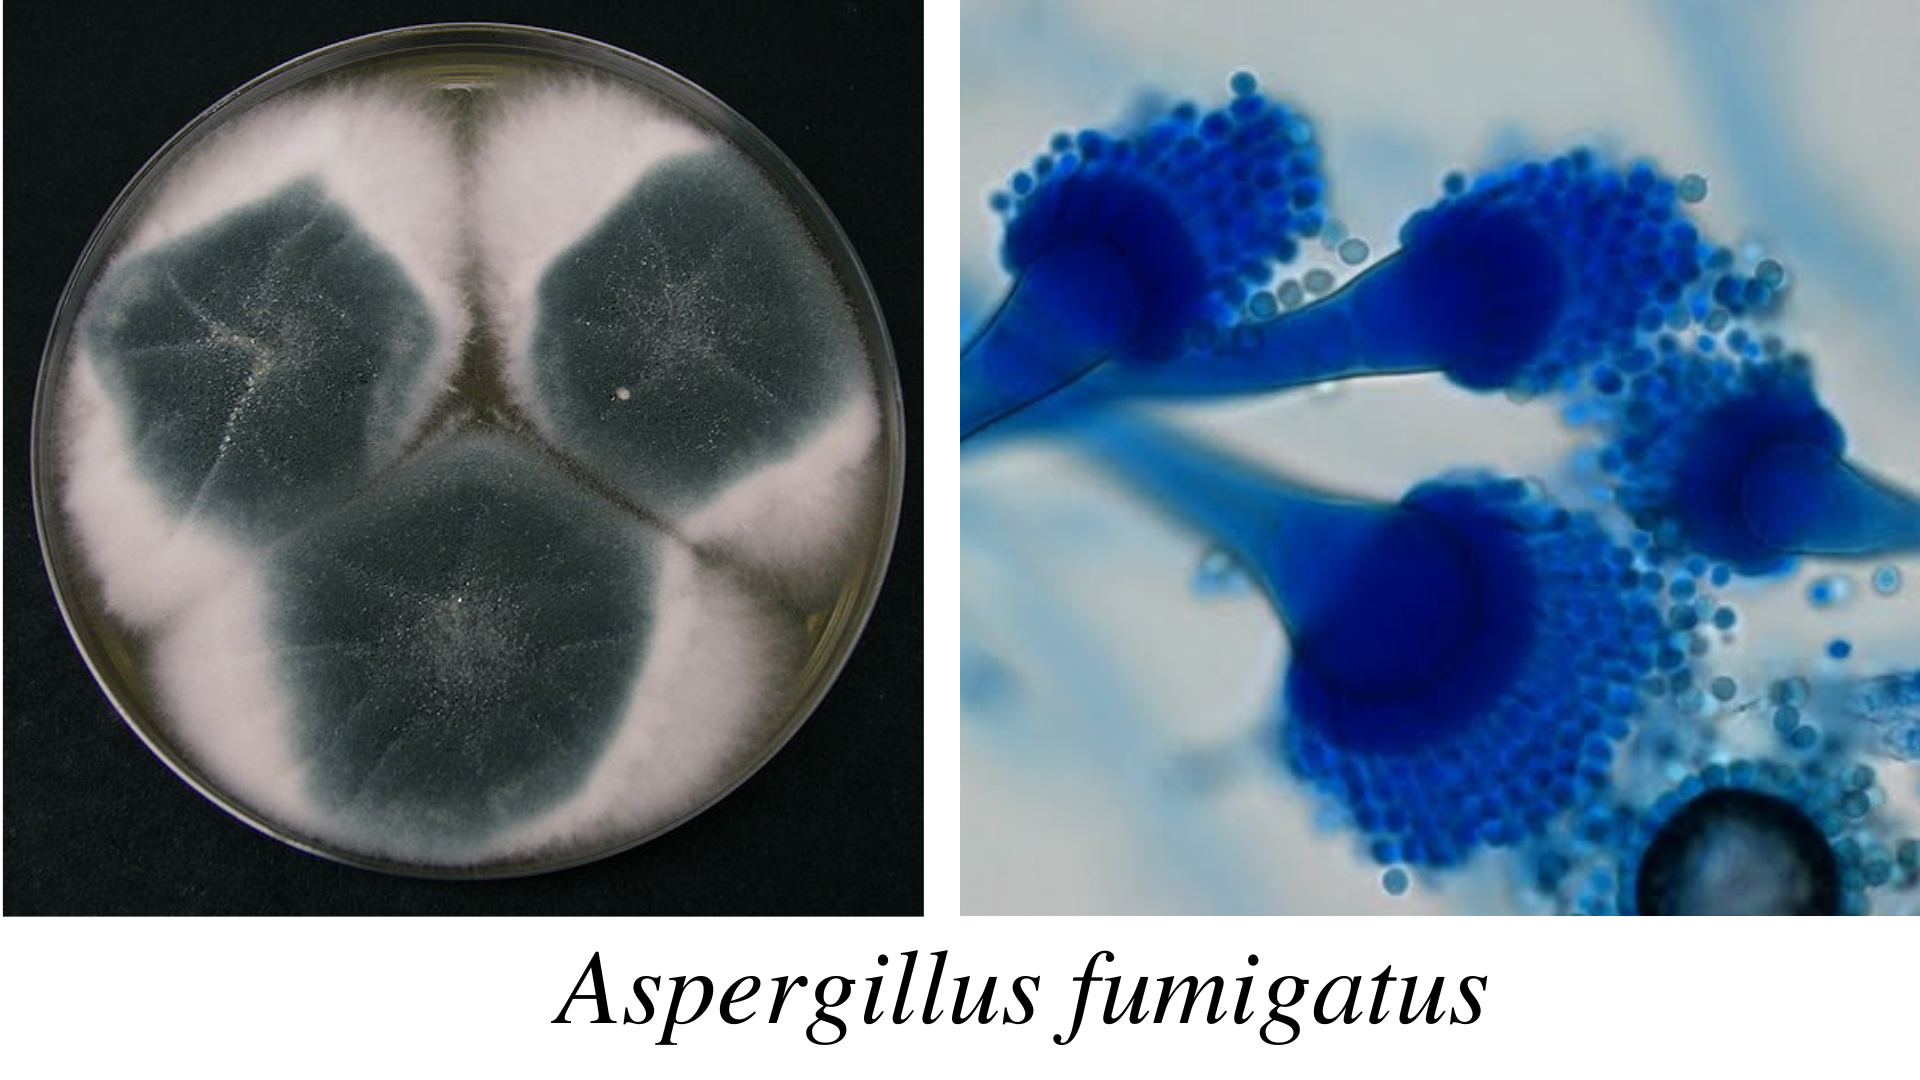
Aspergillus fumigatus - Aspergillus fumigatus
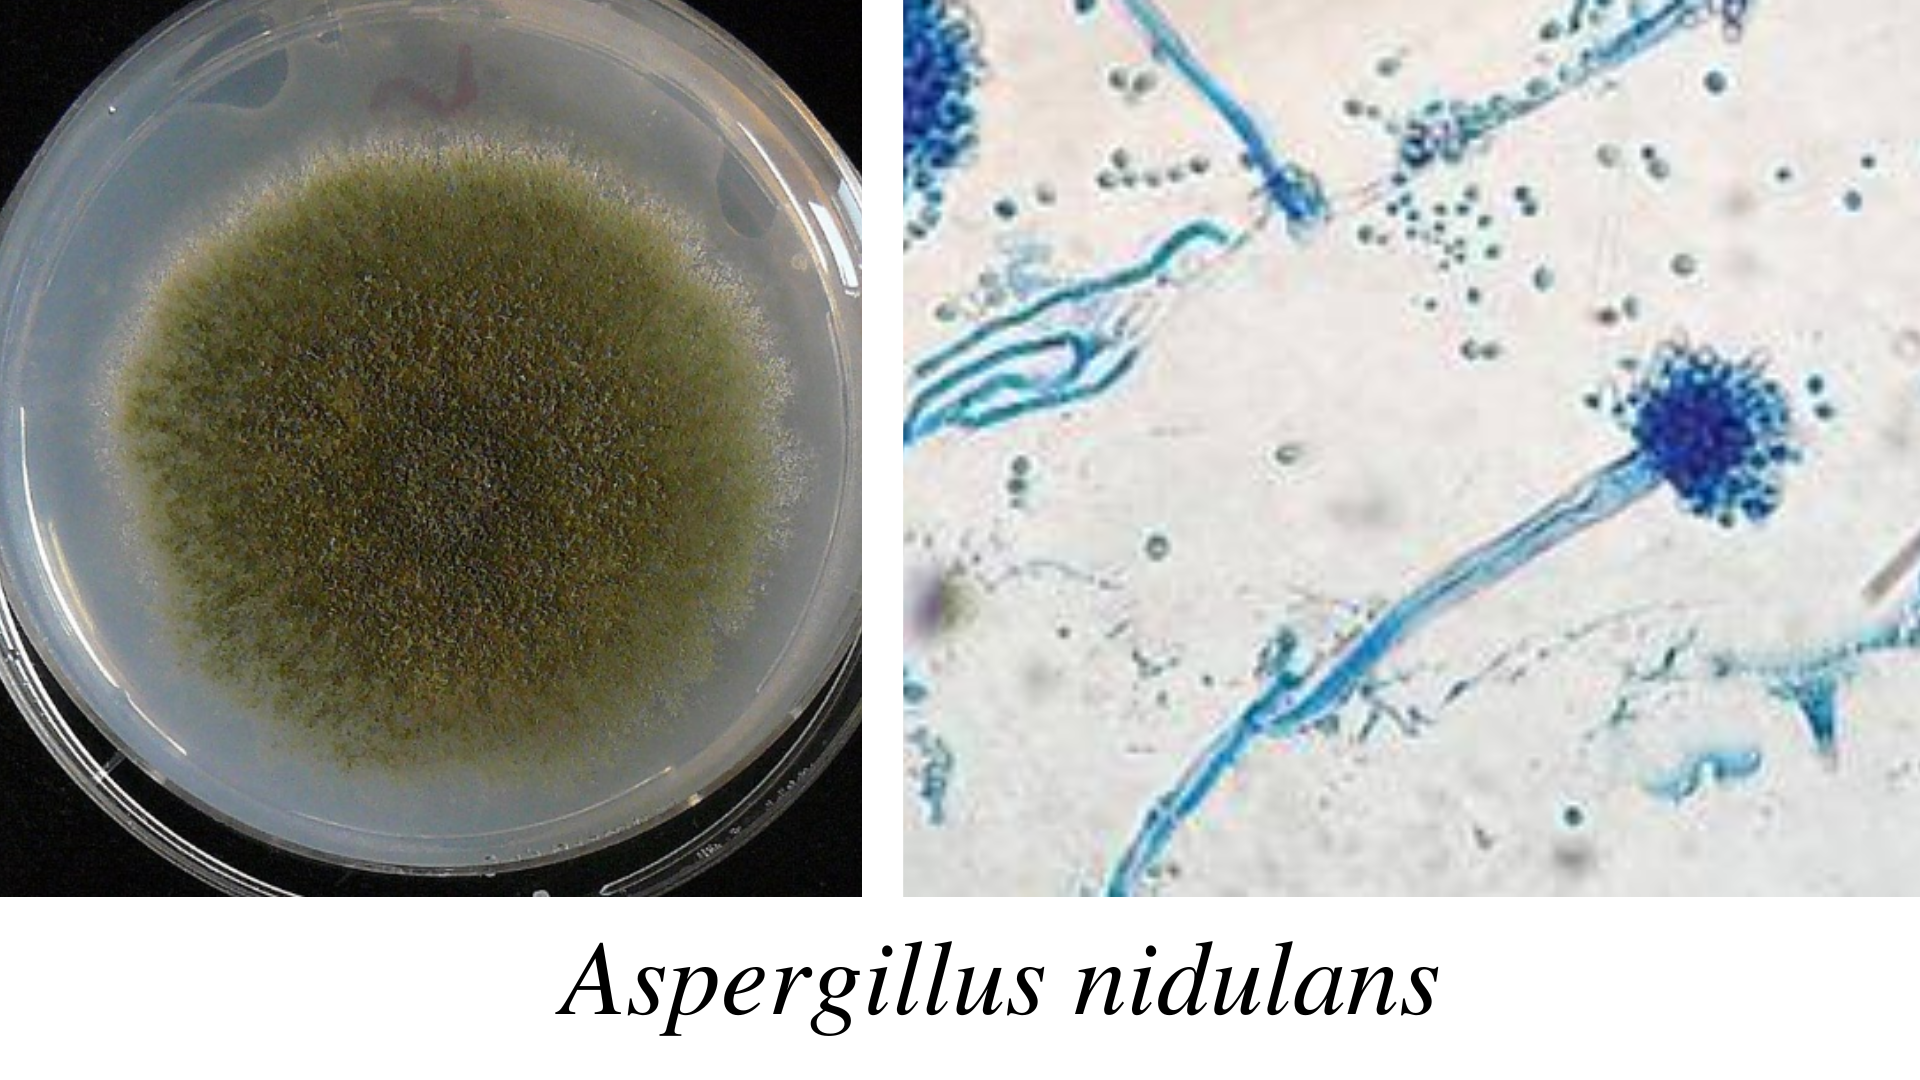
Aspergillus nidulans - Aspergillus nidulans
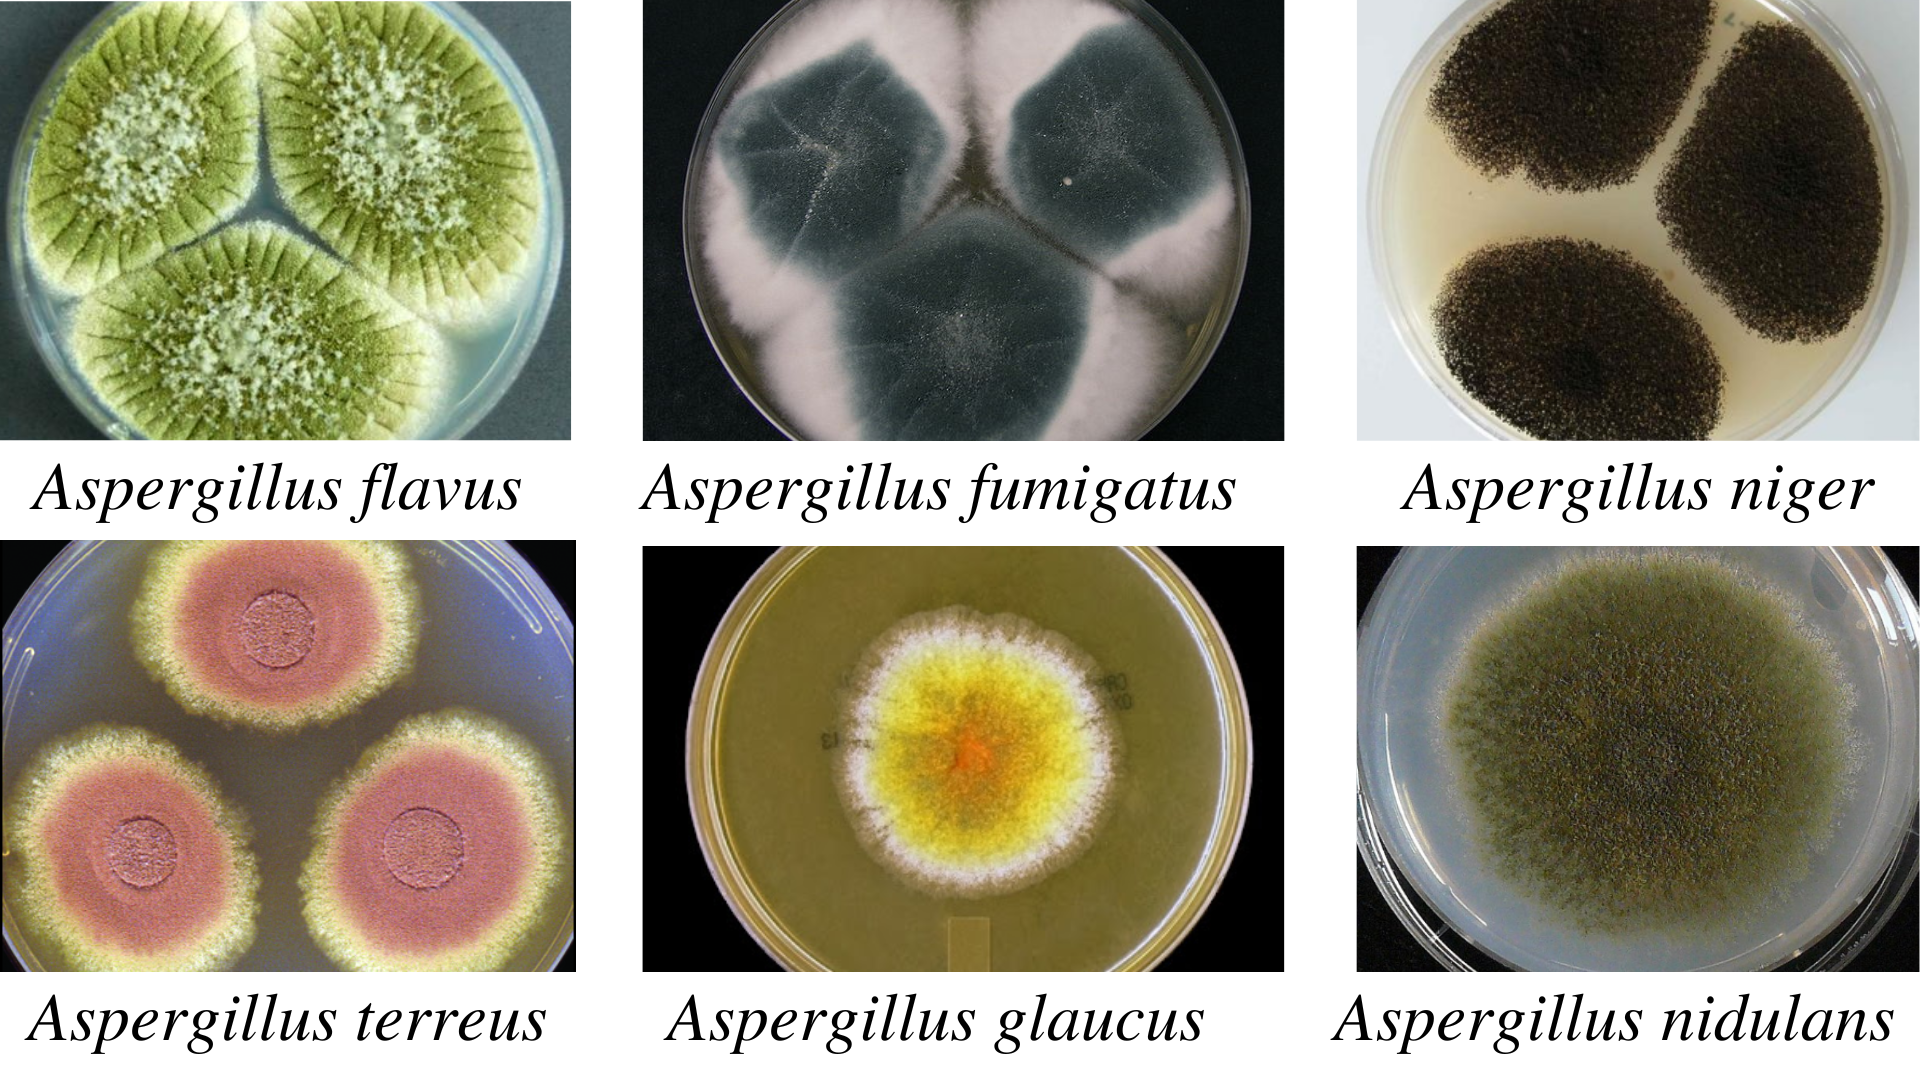
colony morphology of aspergillus spp - Colony morphology ofAspergillusspp.

Aspergillus is a fungus found ubiquitously in the environment. Aspergillus is derived from the Latin word**“Aspergere,”**which means “to scatter”. In 1729, Micheli defined the genus Aspergillus. They are saprophytic mold and are found in decaying organic matter. They grow commonly as the molds on the substrate surface as the contamination in the bread and potatoes. More than 200 species of Aspergillus are found in nature, out of which only about 20 species can cause human disease. Out of these 20, the three most common pathogenic agents in about 95 percent of the cases areAspergillus flavus,A. fumigatus, and Aspergillus niger.
Aspergillus spp. causes aspergillosis, a systemic fungal infection that occurs both in the immunocompromised and the immunocompetent individuals. The sources of infection from the Aspergillusspp.**are soil, air (inhalation of spores), water/storage tanks in hospitals, food, compost, decaying vegetation, fireproofing materials, ventilation, air conditioning systems, and computer fans. It exists as the mold form only. Aspergillus has septate hyphae that form the V-shaped dichotomous branches. The color of the colony on the culture media may be yellow, brown, or black, depending upon the species and its growth condition. There are different species of Aspergillus. They are
- A. flavus
- A. fumigatus
- A. niger
- A.terreus
- A. glaucus
- A.nidulans
- A.oryzae
- A.versicolor
- A.clavatus
- A.philaliseptus
Classification
- Kingdom: Fungi
- Phylum: Ascomycota
- Class: Eurotiomycetes
- Order: Eurotiales
- Family: Trichocomaceae
- Genus: Aspergillus
- Species: *fumigatus, niger, clavatus,*etc.
Aspergillus flavus

A.flavus is a thermotolerant fungus and can grow even in 48℃. It causes infection in the cereals, grains, and legumes. In immunocompromised patients, itcauses otitis, keratitis, sinusitis, and pulmonary and systemic infections. After A.fumigatus, it is the second leading causative agent of aspergillosis. Since its spore’s size isbig** (3-6 µm), it gets deposited in the upper respiratory tract causing fungal sinusitis. It also causes cutaneous infection and non-invasive fungal pneumonia. A.flavus produces aflatoxin, which can cause acute hepatitis, hepatocellular carcinoma, and neutropenia in humans.
Colonies of the A.flavusare velvety, yellow to green or brown. The reverse side is golden to red-brown. The reverse side is golden to red-brown. The conidiophores are of variable length, rough, pitted, and spiny; phialides are single and double, cover the entire vesicle, and point out all directions.
Aspergillus fumigatus
A. fumigatusis a thermophilic fungus, and it can grow at 55℃ and survive up to 70℃. Due to the small size of the conidia, spores reach the alveoli in the lungs. It can germinate to hyphae and cause endothelial damage. It producesgliotoxin, inhibitingphagocytosis, which can evade the immune defense mechanism.Aspergillus fumigatus can infect the skin, eye, and other organs, causing aspergilloma and allergic bronchopulmonary aspergillosis. In the immunocompromised condition, aspergillosis can be fatal, leading to death.
Colonies of the A.fumigatusare velvety or powdery at first, turning to smoky green. The reverse side is white to tan. The conidiophore is smooth, phialides single (uniseriate), usually covering the upper half vesicle parallel to the axis of a stalk.
Aspergillus niger

A.nigeris also known as the black mold and causes infection in food and vegetables. In immunocompromised patients, it can cause invasive pulmonary aspergillosis. People exposed to horticulture are more likely to inhale its spores. A. nigercan also cause otomycosis (infection of the ear). Some of the strains of Aspergillus nigeralso produce the mycotoxins called ochratoxin A.
Colonies of the A. nigerare woolly at first, white to yellow, then dark brown to black. The reverse side is white to yellow. The conidiophore is of variable length; phialides are biseriate, i.e., arranged in two rows, covering the entire vesicle, forming a radiate head.
Aspergillus terreus

A.terreusis also called the *Aspergillus terrestrius.*It is a fungal pathogen of humans, animals, and plants. In potatoes, it causes foliar blight disease. A. terreushas intrinsic AmB resistance in the invitro and invivo conditions. This intrinsic resistance mechanism has challenged antifungal therapy for the treatment of fungal infections.**Morphologically A. terreuscan be distinguished from the other Aspergillusspp. by aleuroconidia which is produced both in invitro and invivo conditions. Similarly, on the other hand, despite being a pathogenic fungal, Aspergillus terreus is being used in cancer therapeutics. It consists of anticancer bioactive compounds such as polyketides.Aspergillus terreusproduces the statin group of polyketides (e.g., lovastatin), which has therapeutic value.
Colonies of the A. terreusare usually velvety cinnamon brown. The reverse side is white to brown. The conidiophores are short and smooth, phialides are in two rows, compactly columnar, and conidia are very small, i.e., 2 µm.
Aspergillus glaucus

A.glaucusis a xerophilic fungus capable of growing at different temperatures. It is osmotolerant fungi and grows in a sugar concentration of 60 %. It can grow as outdoor fungi in winter and even in dry areas with low moisture content. Aspergillus glaucuscan produce mycotoxin. It can cause pneumonitis and also dermatitis.
Colonies of the A.glaucusare green with yellow areas, occasionally brown. The reverse side is yellowish to maroon. The conidiophores are variable in length and smooth. The phialides are single and radiate very loosely columnar.
Aspergillus nidulans
A. nidulans(Emericella nidulans)**are called homothallic fungi because they can fertilize themselves even without a mating partner. It has industrial importance as it produces enzymes like cellulases, hemicellulases, laccases, lipases, proteases, etc.
Colonies of the A.nidulansare typically plain green in color, with dark red-brown cleistothecia developing within and upon the conidial layer. The reverse side may be olive to drab-gray or purple-brown. Colonial heads are short, columnar, and biseriate. Conidiophores are usually short, brownish, and smooth-walled. Conidia are globose and rough-walled.
Clinical Features ofAspergillus
Aspergillus spp. causes aspergillosis. Aspergillosis is a granulomatous, necrotizing, and cavitary disease of the lungs, often with the hematogenous spread to other organs. Tissue invasion or allergic disease occurs in this condition. Depending upon the modes of infection, it can be a primary or secondary infection. Aspergillus spp. can cause superficial infection of skin, nails, external auditory canal, burn eschar, and paranasal sinuses. The various types of clinical conditions caused by Aspergillus spp. are:
- Pulmonary Diseases
- CNS Aspergillosis
- PNS Aspergillosis
- AspergillusEndocarditis
- Cutaneous Aspergillosis
- Miscellaneous Forms
1. Pulmonary Diseases
Pulmonary disease is the disease of the lungs and has following categories:
a) Allergic Aspergillosis
Aspergillus spp. causes bronchial asthma. It results in pulmonary eosinophilia or extrinsic allergic alveolitis. It occurs mainly in atopic persons. The chronic form of the disease is asthma with eosinophilia. It causes decreased lung function and progressive lung damage. The important characteristics of pulmonary disease are lung consolidation and fleeting shadows on chest x-rays.
i) Allergic Bronchopulmonary Aspergillosis (ABPA)
ABPA is caused either by heavy or repeated exposure to spores of Aspergillus spp. In this condition, conidia germinate, and hyphae colonize the bronchial tree. It results in allergic alveolitis and causes breathlessness, fever, and malaise. It then produces the plugs of mycelium (mucous plug) that occludes the lumen. The formation of the mucous plug is the diagnostic feature of the disease. This mucous plug may be coughed out.
ii)Obstructive Aspergillosis
Obstructive aspergillosis causes a progressive cough, no wheezing sound, eosinophilia, and hypoxia.
b)Aspergilloma
People with already preexisting lung cavities are at risk of aspergilloma. The fungus can settle and grow in the cavity. The fungus multiplies and forms the ball in it. Aspergilloma is also called the fungus ball. The colonization of the fungus occurs in the preexisting cavity. Aspergilloma is of various sizes and solitary. Approximately its diameter is 8-10 cm. Radiological diagnosis shows the air crescent or Monod’s sign because it looks like the crescent of air at the upper margin. It is usually asymptomatic or may have a moderate degree of cough and sputum production.
c)Invasive Aspergillosis
At first, the fungus develops pneumonia and then disseminates to other organs like the GI tract, kidney, liver, brain, heart, and other organs producing abscesses and necrotic lesions. There is a widespread growth of fungus in the lung tissue. It can disseminate further to the kidneys and brain. Risk groups include acute leukemia patients, solid-organ transplantation, AIDS, neutropenia, and transplant recipients.
d)Chronic Necrotizing Pulmonary Aspergillosis (CNPA)
In the immunocompromised host, CNPA or semi-invasive pulmonary aspergillosis may create its cavity. Then it grows as a non-invasive organism.
2. Central Nervous System (CNS) Aspergillosis
It is a fungal infection in which aspergillosis occurs in the central nervous system. Most cases occur by the hematogenous dissemination from pulmonary or gastrointestinal focus. The causative agent****of CNS aspergillosis are Aspergillus fumigatus, A.flavus, A.terreusand A. versicolor.
Clinical manifestations of CNS aspergillosis are
- Abscesses to granulomas
- Rhinocerebral form to meningitis
- Intracranial mass lesions (solitary or multiple)
- Ventriculitis
The cranial and intracranial invasion also occurs following the infection within the sinuses. The different ****clinical syndromes observed are:
- Encephalitis
- Meningoencephalitis
- Stroke like syndrome
- Intracranial space-occupying lesion
- Skull base syndrome
- Intra-orbital space-occupying lesion
3. Paranasal Sinuses (PNS) Aspergillosis
**PNS Aspergillosis is the colonization and invasion of the paranasal sinuses byAspergillusspp. Its types are: allergic, non-invasive, invasive, and fulminant.
- **Allergic form:**It is similar to ABPA. It combines Type I and Type III hypersensitivity to Aspergillus antigens.
- **Non-invasive form:**It results from the formation of aspergilloma. It behaves as chronic sinusitis.
- **Invasive form:**It behaves like malignant neoplasia. It is slowly progressive and locally destructive.
- **Fulminant form:**It is angioinvasive and rapidly destructive. The infection spreads from bone to the orbit of the eye and brain.
4. Aspergillus Endocarditis
In immunocompromised patients and persons with prior cardiac surgery, Aspergillus species may cause endocarditis. The large fungal vegetation occurs on heart valves. Fever and multiple embolic strokes can occur. Successful treatment depends on effective antifungal therapy and surgical removal of the infected tissue.
5. Cutaneous Aspergillosis
It is an infection of the skin and occurs by direct inoculation from trauma or surgery. It may be inoculated from objects like arm boards and external catheter sites. Primary cutaneous aspergillosis includes nodules, molluscum-like papules, plaques, and ulcers. Secondary cutaneous aspergillosis usually occurs on the chest wall. Cutaneous aspergillosis occurs in neutropenic cancer patients, neonates, and HIVpatients.
Superficial infections: Aspergillus flavusand Aspergillus fumigates colonize the paranasal sinuses, i.e., sinusitis, external ear (otomycosis)
6. Miscellaneous Forms
The other forms are keratomycosis, endophthalmitis, onychomycosis, mastoiditis, and osteomyelitis.
Laboratory Diagnosis of Aspergillosis
The presumptive assumption of the fungus is made based on the colony morphology, and for the definitive identification, microscopic observation of hyphae and the conidial head is done. The conidial head consists of conidiophores.
Sample
For the laboratory diagnosis of aspergillosis, the specimen of choice is sputum, sinus drainage, bronchial washing, bronchoalveolar lavage (BAL) fluid, a biopsy of the infected area (lung), and skin scraping.
1. Direct Examination
For the direct examination of the Aspergillusspp. 10 %, KOH wet mount is prepared. Then microscopic observation of the Aspergillus spp. is done. The hyphae of the Aspergillusspp. are hyaline and septate. Its diameter is 3-6µm, and dichotomous branching (type of branching in which two branches are approximately equal in size).
A biopsy is also taken in the case of fungal granuloma. For the examination, biopsy material should be kept in a tube of KOH. It is then incubated overnight at 37°C. For the histological examination of the biopsy material, the preferable staining methods are Hematoxylin and Eosin, Periodic Acid-Schiff, and Grocott-Gomori’s methenamine silver stain. Hyphae appear branched at a nearly 45-degree angle. Finger-like appearance is seen in the branching elements. In invasive aspergillosis, a proliferation of hyphae is seen throughout the tissue. It occurs in parallel or radial arrays. Aspergilli colonizing pulmonary cavity lesions grow as tangled masses of hyphae.
The chronic infection may exhibit atypical hyphal features. Swelling may be seen in this condition, up to 12µm in diameter. Similarly, there may be an absence of conspicuous septa in this condition, as seen in the Aspergillusfungus balls.
2. Fungal Culture
Different media used for the fungal culture are Sabouraud Dextrose Agar (SDA), Potato Dextrose Agar (PDA), Czapek Dox Agar, and Malt extract agar. Inoculation is done in SDA agar with antibiotics and without cycloheximide at 25°C and 37°C, respectively. The isolate can be subcultured on the Czapek Dox agar and 2% Malt Extract Agar and incubated at 25°C. For the induction of the sporulation, PDA can be used. Culture should be examined after 48 hrs of inoculation. Then it should be examined daily for a week, twice a week for further four weeks, before discarding the plate. Colonies of different Aspergillus spp. produces different colors.
Colony morphology ofAspergillusspp
| Species | Colonies | Reverse |
|---|---|---|
| A. flavus | Velvety, yellow to green or brown | Golden to red-brown |
| A.fumigatus | Velvety or powdery at first, turning to smoky-green | White to tan |
| A. niger | Woolly white to yellow at first, turning to dark brown to black | White to yellow |
| A. terreus | Velvety cinnamon brown | White to brown |
| A. glaucus | Green with yellow areas, occasionally brown | Yellowish to maroon |
| A. nidulans | Plain green in color with dark red-brown cleistothecia | Olive to drab-gray or purple-brown |
Microscopic observation ofAspergillusspp

| Species | Phialides | Color of Conidia |
|---|---|---|
| A. fumigatus | Uniseriate | Grey, green or blue-green |
| A. flavus | Biseriate or Uniseriate | Yellow to green |
| A.niger | Biseriate | Black |
| A.terreus | Biseriate | Orange to brown |
| A. nidulans | Biseriate | Dark green |
Aspergillus spp. is a common laboratory contaminant. So, to confirm the relevance of positive culture, their quantitation is necessary. For this, 6-consecutive morning samples are required, out of which should show the same fungal growth in the 50% sample.
3. Immunodiagnosis
In the case of aspergilloma, a high percentage of patients demonstrates precipitating IgG antibodies. In case of allergic bronchopulmonary aspergillosis:
- Skin test reaction is positive for Aspergillusantigens.
- Elevated level of IgE
- Specific IgE and IgG precipitating antibodies to Aspergillusspp. in serum.
i. Detection of Antibody
An immunodiffusion test is done using commercial or laboratory-prepared antigens. Biotin-avidin-linked enzyme immunoassay (BALISA)****is a sensitive enzyme-linked immunosorbent assay that uses biotin-avidin amplification systems. It is used for the demonstration of antibody isotypes. Antigens used are the crude culture filtrate, cell wall, or cytoplasmic extracts ofA. fumigatus.
ii. Detection of Antigen
This test is useful for the detection of the antigen in immunosuppressed patients. In that condition, demonstrable antibodies may be absent in them. In invasive infection, antigen detection is useful. Various tests can detect the soluble antigen in the serum, urine, body fluids, and within-host phagocytic cells. They are:
- Latex agglutination test
- RIA
- ELISA and BALISA
For the demonstration of theAspergillus antigens in the cerebrospinal fluid, western blot analysis was done by Ray and colleagues.
iii. Molecular Techniques
**Different molecular techniques for the detection of theAspergillus spp. are DNA probes, DNA sequencing, PCR(real-time PCR), and nested PCR assay
iv. Molecular Typing
Molecular typing is based on the phenotypic and genotyping characters. Typing based on the phenotyping characters is based on antigens, enzymes, morphology, and biochemistry. Typing based on genotyping methods involves analysis of genomic DNA, mitochondrial DNA (mtDNA), and ribosomal DNA (rDNA). Restriction fragment length polymorphism (RFLP) involves restriction endonucleases that cleave the DNA on specific sequences.
v. Detection of Fungal Metabolites
For the detection of the fungal metabolites, G-test is done. G-test helps to detect circulating β-(1,3)-D-glucan.Aspergillus galactomannan (the cell wall content) is used as an indicator mannitol as a marker diagnosis of invasive aspergillosis.
vi. Skin Tests
A skin test is done for patients with suspected allergic bronchopulmonary aspergillosis, atopic dermatitis, or allergic asthma. The 0.1 ml antigen (1000 PNU/ml aspergillin) is given intradermally for this test.
Results:
- Type I hypersensitivity: Erythema and wheal within 1 hour.
- Type III: Arthus reaction within 4-10 hours develops.
- Type IV reaction: induration >5mm diameter after 24 hours.
4. Animal Pathogenicity
Rabbits and mice are model animals for testing the pathogenicity of the Aspergillus spp. Conidia are injected intravenously, which results in granulomatous lesions in various organs, especially in kidneys.
Prevention
Mostly immune-compromised individuals and persons with severe lung diseases are at risk of the infection. To prevent aspergillosis, the best way is to avoid exposure to the Aspergillus spp. Some of the approaches one can consider to reduce exposure to fungal infections are as follows:
- Avoid direct and close contact with the soil or dust, such as during fieldwork or gardening. While going to the construction sites close to the soil, wear a mask properly. It will help to reduce the chances of inhalation of the conidia directly from the vegetation.
- To improve the quality of air, use HEPA filters.
- Use soap and water to clean the skin injury exposed to the soil.
Treatment
For the treatment of the fungal infection caused byAspergillus, different antifungal agents such as voriconazole, itraconazole, or amphotericin B are used. Voriconazole is found to be more effective than amphotericin B.
- Aspergilloma: Itraconazole, Amphotericin B
- Invasive aspergillosis: Voriconazole
- ABPA: Steroids with anti-fungal agents
- Allergic aspergillosis: Corticosteroids with sodium cromoglycate
References
- Abdin, M. Z., Ahmad, M. M., & Javed, S. (2010). Advances in molecular detection of Aspergillus: An update. Archives of Microbiology, 192(6), 409–425. https://doi.org/10.1007/s00203-010-0563-y
- Cadena, J., Thompson, G. R., & Patterson, T. F. (2016). Invasive Aspergillosis: Current Strategies for Diagnosis and Management. Infectious Disease Clinics of North America, 30(1), 125–142. https://doi.org/10.1016/j.idc.2015.10.015
- Chander, J. (2018). Textbook of Medical Mycology (Fourth edition). Jaypee Brothers Medical Publishers Ltd.
- Sharma, S., Dubey, S. K., Kumar, N., & Sundriyal, D. (2013). “Monod” and “air crescent” sign in aspergilloma. BMJ Case Reports, 1–2. https://doi.org/10.1136/bcr-2013-200936